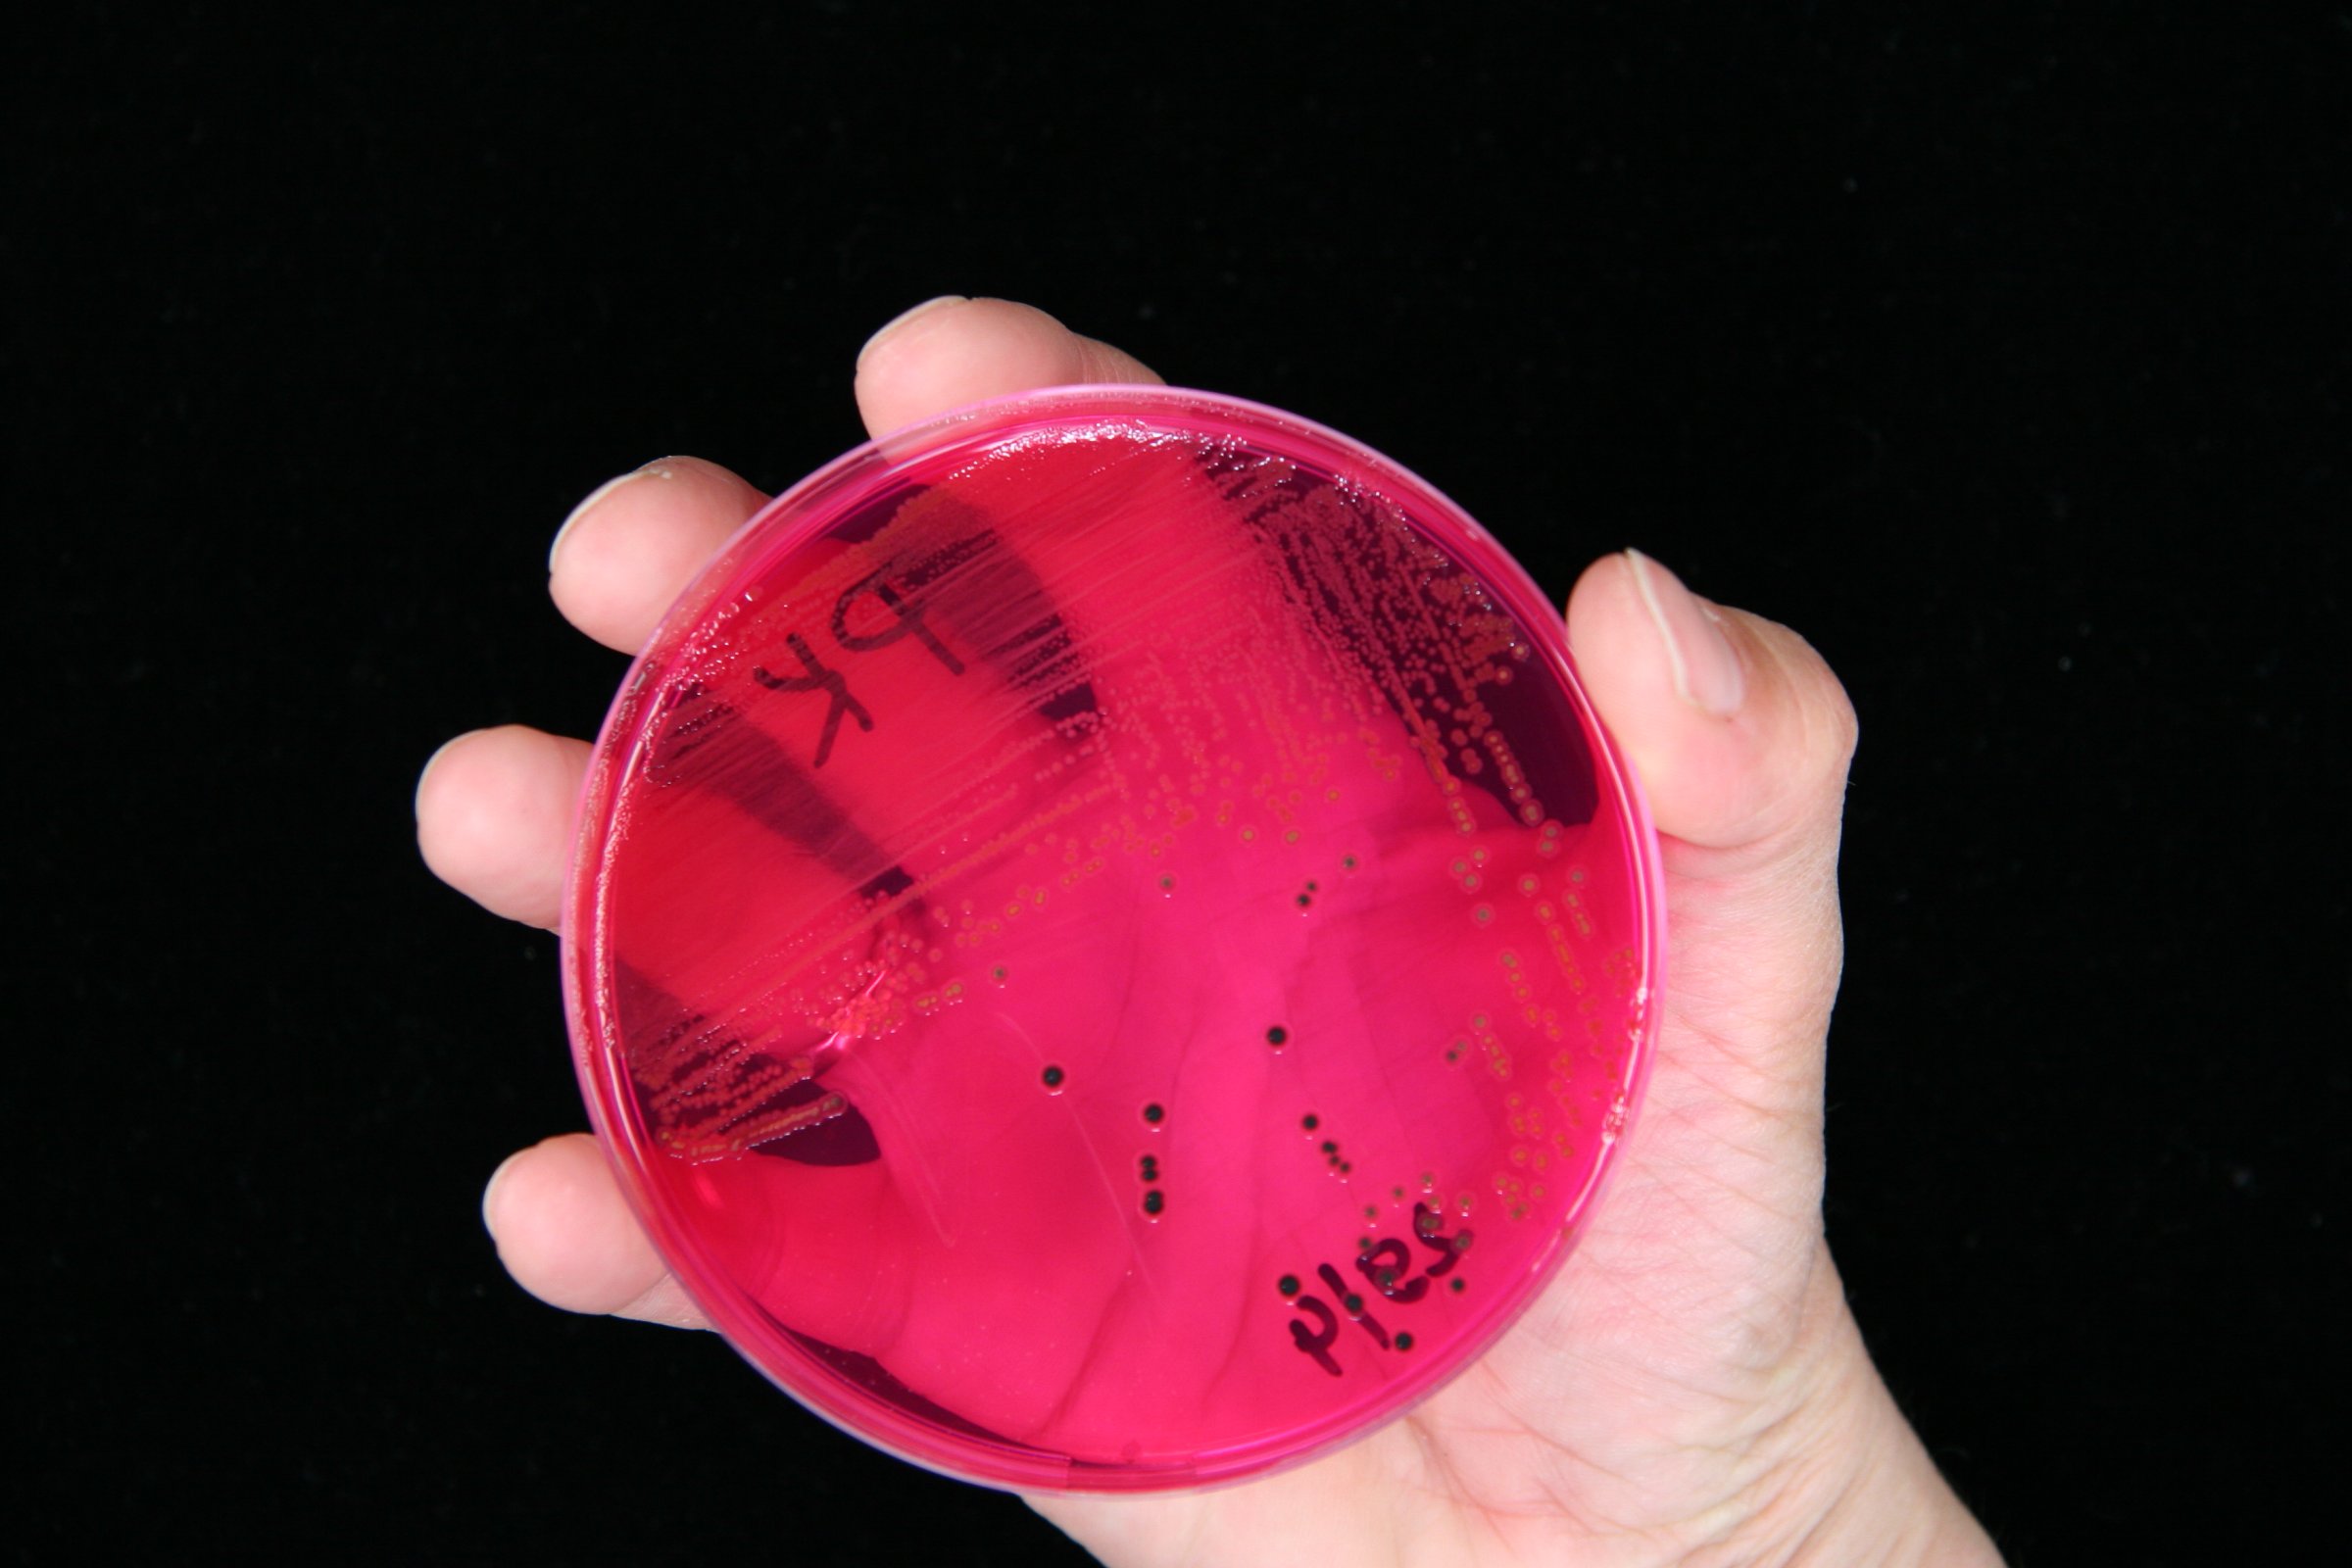

Europeisk rapport viser høyt resistensnivå i bakterier som forårsaker matbårne infeksjoner
En betydelig andel av Salmonella- og Campylobacter-bakterier er resistente mot antibiotika ofte brukt hos mennesker og dyr, viser en rapport fra European Center for Disease Prevention and Control (ECDC) og European Food Safety Authority (EFSA).
Rapporten er basert på overvåkingsdata for antimikrobiell resistens samlet inn av medlems- og EØS-landene som del av EUs regulatoriske forpliktelser. Veterinærinstituttet har levert data for dyr og mat i Norge på vegne av Mattilsynet. Disse nasjonale dataene er også presentert i NORM-VET-rapporten for 2019.
–I forhold til helhetsbildet for Europa som kommer fram i denne rapporten, er Norge annerledeslandet, sier seniorforsker ved Veterinærinstituttet, Anne Margrete Urdahl, som leder arbeidet med NORM-VET i Norge. Husdyrepopulasjonen i Norge er regnet som fri for Salmonella, og de fleste av Salmonellatilfellene hos folk i Norge er smittet utenlands, forklarer hun.
Økning i visse resistenstyper
Hos en spesifikk Salmonella-type kjent som S. Kentucky isolert fra mennesker, var det en høy andel resistens mot ciprofloxacin (82,1%), et fluorokinolon som ofte brukes til å behandle flere typer infeksjoner. Også hos S. Enteritidis har det de siste årene blitt rapportert en økende trend i (fluoro)kinolonresistens i flere land. Den økende forekomsten av (fluoro)kinolonresistens hos disse Salmonella-typene gjenspeiler sannsynligvis en spredningen av spesielt motstandsdyktige stammer.
Hos Campylobacter er resistens mot ciprofloxacin nå så vanlig i de fleste land at detteantibakterielle middelet nå har en begrenset bruk ved behandling av Campylobacter-infeksjoner hos mennesker.
–I Norge har forekomsten av resistens mot fluorokinoloner slik som ciprofloxacin generelt ligget lavt sammenliknet med mange andre land. Imidlertid har det også i Norge de siste 10 årene vært en økende trend i forekomst av fluorokinolonresistens hos Campylobacter spp. fra produksjonsdyr, sier Urdahl. Det er uklart hvorfor vi har en slik økning da det er et svært lavt forbruk av kinoloner, fortsetter hun.
Noen gladnyheter
Rapporten inneholder imidlertid også noen positive funn. I løpet av perioden 2015-2019, har det vært en nedgang i resistens mot ampicillin og tetracykliner hos Salmonella-isolater fra mennesker i hhv. åtte og elleve land.
Det er også en nedadgående trend i forekomsten av utvidet spektrum β-laktamase(ESBL) - produserende E. coli i prøver fra matproduserende dyr i 13 land mellom 2015 og 2019. Dette er et bra resultat da enkelte stammer av ESBL-produserende E. coli kan forårsake alvorlige infeksjoner hos mennesker.
Kombinert resistens mot to kritisk viktige antimikrobielle stoffer - fluorokinoloner og tredje generasjon cefalosporiner hos Salmonella, og fluorokinoloner og makrolider hos Campylobacter - er fortsatt lave. Disse kritisk viktige antimikrobielle stoffene brukes ofte til å behandle alvorlige infeksjoner fra Salmonella og Campylobacter hos mennesker.
I perioden 2014-2019, er det i ni av landene en økning i andelen av E. coli-bakterier i prøver fra matproduserende dyr som er fullt følsomme for alle de antimikrobielle stoffene det testes for.